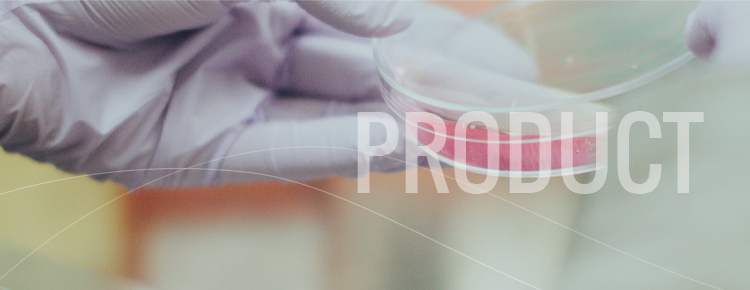

天天干天天插
|
黄色影视在线观看
|
国产精品视频久久久久
|
狠狠干很很操
|
欧美色图综合网
|
91极品蜜桃臀
|
国产中文字幕免费
|
亚洲第一色网
|
大尺度做爰呻吟62集
|
挪威xxxx性hd极品
|
亚洲成人午夜电影
|
中文字幕在
|
www一区二区
|
综合免费视频
|
黑料av在线|
99这里只有精品
|
精品久久久久一区二区国产
|
a√天堂资源
|
天天看夜夜看
|
新婚之夜玷污岳丰满少妇在线观看
|
91香蕉国产|
a视频在线免费观看
|
亚洲精品一二三四
|
在线视频97
|
a天堂在线资源
|
久草成人在线视频
|
久久亚洲国产精品
|
女人脱了内裤趴开腿让男躁
|
www网站在线观看
|
亚洲深夜
|
97干视频|
国产香蕉网
|
9.1在线观看免费
|
加勒比综合|
欧美激情视频网站
|
黄色片成年人
|
av黄色在线免费观看
|
青青青视频在线播放
|
国产精品久久久久久久久久免费看
|
91丝袜在线
|
综合影院
|
未满十八18禁止免费无码网站
|
人人插人人干
|
欧美做受视频
|
韩国av一区
|
激情欧美一区二区三区
|
让男按摩师摸好爽
|
国产女无套免费视频
|
久草福利视频
|
丰满熟妇人妻中文字幕
|
日日骚av|
免费视频色
|
日韩69|
国产欧美日韩久久
|
婷婷五月综合久久中文字幕
|
加勒比综合
|
国产色播
|
国产又粗又大又硬
|
制服丝袜综合
|
在线视频97
|
夜夜操夜夜
|
免费a级黄色片
|
99re这里只有精品6
|
免费观看91视频
|
亚洲一区,二区
|
国产中文一区
|
91导航|
婷婷狠狠操
|
欧美大尺度做爰啪啪床戏明星
|
免费国产|
日本黄a三级三级三级
|
国产剧情一区二区
|
激情导航|
牛av在线
|
欧美成人免费观看视频
|
日本黄色中文字幕
|
久久精品操
|
青青操在线
|
啪啪在线视频
|
强睡邻居人妻中文字幕
|
蓝猫淘气三千问恐龙时代
|
久久精品播放
|
久久草视频
|
亚洲一区国产
|
婷婷在线免费视频
|
女人脱了内裤趴开腿让男躁
|
18深夜在线观看免费视频
|
欧美毛片基地
|
99久久久成人国产精品
|
免费av播放
|
日本少妇xxxx软件
|
百合sm惩罚室羞辱调教
|
黄视频免费观看
|
欧美午夜视频在线观看
|
日韩专区第一页
|
av在线播放地址
|
日韩熟女一区二区
|
亚洲午夜小视频
|
亚洲中文字幕一区二区
|
日韩中文一区二区
|
国产福利视频一区二区三区
|
人人干天天操
|
久久午夜鲁丝片
|
国产精品资源
|
亚洲三级中文字幕
|
黄色茄子视频
|
伊人天堂av|
午夜性福利视频
|
国内久久精品
|
日本wwww色
|
国产精品国产精品国产专区蜜臀ah
|
亚洲高清一区二区三区
|
国产码视频
|
亚洲视频天堂
|
人人插人人干
|
日韩中文一区二区
|
av中文网|
青娱乐伊人
|
亚洲一区在线观看视频
|
国产精品视频网址
|
艳妇乳肉豪妇荡乳av无码福利
|
欧美成人免费观看视频
|
国产成人精品亚洲线观看
|
精品久久久久久久久久久久久久
|
国产成人影视
|
亚洲免费一级片
|
一级国产黄色片
|
亚洲成人精品
|
成人h文
|
老熟妇一区二区三区啪啪
|
性欧美hd调教
|
亚洲一区二区在线免费观看
|
琪琪色影音先锋
|
免费av网站观看
|
夜夜操夜夜
|
美女免费av
|
av综合站
|
成人精品区
|
国产精品九九九
|
a级片在线免费观看
|
秋霞午夜鲁丝一区二区老狼
|
男女做羞羞的视频
|
白嫩白嫩国产精品
|
亚洲偷偷
|
欧美性一级
|
福利在线播放
|
美国一级黄色大片
|
韩国成人免费视频
|
欧洲xxxxx|
日韩videos
|
av在线网页|
亚洲精品一二三四
|
蜜臀av一区二区
|
国产精品久久久久精
|
宝贝乖~胸罩脱了让我揉你的胸
|
国产三级视频
|
国产福利视频一区二区三区
|
中文字幕第一区综合
|
久久手机免费视频
|
精品999视频
|
岛国大片在线免费观看
|
日本黄色免费电影
|
亚洲AV无码一区二区三区少妇
|
亚洲国产91|
国模精品视频
|
美女黄色影院
|
在线观看免费人成视频
|
天天摸天天操
|
色一区二区三区
|
男女在楼梯上高潮做啪啪
|
欧美日韩在线免费
|
激情视频网址
|
制服丝袜中文字幕在线观看
|
好色视频tv
|
激情视频网址
|
无码视频在线观看
|
国产真人做爰视频免费
|
www.黄色国产
|
欧美美女喷水
|
婷婷伊人|
美女免费视频网站
|
波多野吉衣一二三区乱码
|
日本啪啪网
|
欧美三日本三级少妇99
|
网爆门在线
|
男女69视频
|
国产亚洲小视频
|
www.狠狠操.com
|
波多野结衣简介
|
www.麻豆av.com|
超碰免费在线观看
|
亚洲精品视频在线看
|
99re这里只有精品6
|
h片在线播放
|
久久人人爽人人爽人人片亚洲
|
亚洲精品久久久久久动漫器材一区
|
高清视频一区二区
|
黄色片在哪里看
|
亚洲AV无码精品久久一区二区
|
69堂在线观看
|
曰本无码人妻丰满熟妇啪啪
|
国产女无套免费视频
|
老熟妇一区二区三区啪啪
|
91网站在线免费看
|
嫩草影院懂你的影院
|
丰满肉嫩西川结衣av
|
亚洲日本韩国在线
|
亚洲午夜网站
|
中文字幕一区二区人妻在线不卡
|
视频污在线观看
|
新中文字幕
|
精品久久久久久中文字幕
|
中文字幕免费视频
|
欧美激情视频网站
|
一区二区午夜
|
宝贝乖~胸罩脱了让我揉你的胸
|
午夜噜噜噜
|
韩国三级hd中文字幕叫床浴室
|
精品久久久久久久久久久久久久
|
桃谷绘里香在线观看
|
午夜精品久久久久久久99热黄桃
|
日本黄色片在线观看
|
欧美日韩在线一区二区
|
日韩成人在线播放
|
亚洲国产网站
|
成人免费精品视频
|
久草福利视频
|
黄色三级小说
|
精品热久久
|
亚洲综合激情五月久久
|
日本美女三级
|
啪啪免费
|
亚洲在线日韩
|
精品久久久久久久久久久久久久
|
成年人网站免费观看
|
久久久国产精品视频
|
日日夜夜狠狠干
|
人妻体体内射精一区二区
|
91一区在线
|
日韩每日更新
|
欧美日韩一区二区精品
|
丰满岳乱妇在线观看中字无码
|
亚洲不卡视频在线观看
|
美国av导航
|
91国视频|
嫩草影院在线免费观看
|
国产福利视频一区二区三区
|
国产va视频
|
男女做羞羞的视频
|
日韩av在线网
|
日本天堂网在线观看
|
青草视频在线观看免费
|
色综合综合色
|
韩国三级hd中文字幕叫床浴室
|
91国产一区
|
伊人天堂av
|
中文字幕看片
|
国产精品看片
|
中文字幕在线观看网址
|
亚洲专区av
|
美女在线播放
|
亚洲电影第1页
|
老司机黄色片
|
秋霞免费av
|
深夜影院在线观看
|
精品久久久久久久久久久
|
亚洲精品久久久久久动漫器材一区
|
亚洲在线日韩
|
国产污污视频
|
久草热在线观看
|
久久99久久99精品免观看粉嫩
|
99热99|
国产天堂在线观看
|
日韩一级黄色大片
|
日夜夜操
|
国产人妖一区
|
91av网址
|
91视频美女
|
精品999视频
|
99re只有精品
|
久操资源
|
国产精品主播一区二区
|
亲女小嫩嫩h乱视频
|
亚洲综合色一区
|
爱爱一区二区三区
|
韩国黄色一级片
|
色呦呦国产|
美国一级黄色大片
|
久久久综合视频
|
青娱乐99
|
波多野结衣av在线播放
|
婷婷五月综合久久中文字幕
|
成人久久精品人妻一区二区三区
|
不卡的av在线播放
|
三上悠亚一区二区
|
hs视频在线观看
|
日本高清视频免费看
|
欧美性视频网站
|
91高清免费|
a天堂在线观看视频
|
可以免费看黄的网站
|
视频黄页在线观看
|
亚洲欧美日韩精品永久在线
|
www.色播|
欧美色拍|
日韩av在线网
|
国产精品久久久精品
|
天天摸夜夜添
|
日韩三级一区二区三区
|
日本在线www
|
一级黄色在线观看
|
91久久在线|
国产日韩欧美亚洲
|
在线看片福利
|
一区二区午夜
|
日本少妇一区二区三区
|
sm久久捆绑调教精品一区
|
色网站在线观看
|
日本不卡网
|
日韩三级视频在线观看
|
欧美一区二区在线观看视频
|
国产精品伊人
|
波多野结衣一二三区
|
熟女俱乐部一区二区视频在线
|
日本少妇一区二区三区
|
草草影院第一页
|
福利精品在线
|
亚洲精品一区二区三区新线路
|
黄色影视在线观看
|
秋霞国产午夜精品免费视频
|
久操社区
|
天堂a√在线|
国产精品天天狠天天看
|
免费一级淫片
|
欧美人与性动交g欧美精器
欧美少妇bbb
|
韩国av一区二区
|
啪啪免费网站
|
gogo人体做爰大胆裸体
|
亚洲综合激情小说
|
精品国产成人亚洲午夜福利
|
裸体毛片|
亚洲免费大片
|
午夜有码
|
成人午夜视频网站
|
gogo人体做爰大胆裸体
|
国内黄色片|
国产av无码专区亚洲av
|
午夜在线免费观看
|
欧美午夜不卡
|
白袜免费网站xx视频
|
奇米影视一区二区三区
|
欧美高清精品
|
奇米影视奇米色
|
欧美做受视频
|
黄色日批|
婷婷五月综合久久中文字幕
|
成人av在线影院
|
红桃视频国产精品
|
国产va视频|
草草影院第一页
|
手机看片在线观看
|
激情成人av|
黄色影视在线观看
|
亚洲日本一区二区
|
亚洲成年人av
|
欧美黄色大全
|
色狠狠一区二区三区香蕉
|
新婚之夜玷污岳丰满少妇在线观看
|
国产一级黄色电影
|
日本久久中文字幕
|
国产剧情一区二区
|
精品久久久久久久久久久久久久
|
免费av导航
|
欧美激情一区二区三区
|
一级片特黄
|
国内久久精品
|
丝袜美腿亚洲综合
|
久久香蕉网站
|
国产精品九九九
|
日本黄色电影网站
|
91免费视频网站
|
日本黄页视频
|
99re只有精品
|
日本少妇在线
|
岳睡了我中文字幕日本
|
亚洲午夜网站
|
欧美日韩一区二区精品
|
国产欧美一区二区视频
|
成人精品网址
|
波多野吉衣一二三区乱码
|
美女作爱网站
|
国产在线观看a
|
日韩一级黄色
|
黄色在线
|
日本精品视频在线观看
|
女人脱了内裤趴开腿让男躁
|
国产乱码一区二区
|
免费视频色
|
亚洲免费观看
|
亚洲最新
|
激情导航|
免费观看黄色网址
|
亚洲国产91|
一区二区三区av
|
高中男男gay互囗交观看
|
吃奶动态图
|
男人久久
|
亚洲AV无码精品久久一区二区
|
黄色茄子视频
|
高潮毛片无遮挡
|
一本久久综合
|
久草视频免费在线观看
|
精品国产一区二
|
99精品一级欧美片免费播放
|
国产日韩av一区二区
|
欧美日韩资源
|
欧美你懂的
|
男生桶女生肌肌
|
稀缺呦国内精品呦
|
中文字幕在线观看网址
|
91看片在线播放
|
欧美一区二区三区视频在线观看
|
日日摸日日碰
|
国产精品偷伦视频免费观看了
|
亚洲综合色一区
|
羞羞网站
|
激情欧美一区二区三区
|
另类图片亚洲色图
|
超碰资源
|
在线免费观看中文字幕
|
国产乱子伦精品视频
|
秋霞福利网
|
国产污污视频在线观看
|
国产在线黄
|
欧美成人精品一区二区男人看
|
91网站在线免费看
|
黄色一级片网站
|
双性懵懂美人被强制调教
|
亚洲依依|
黑人精品一区二区
|
欧美一级在线免费观看
|
天堂在线资源网
|
韩国三级黄色
|
少妇又紧又深又湿又爽视频
|
视频污在线观看
|
另类二区|
北条麻妃中文字幕
|
男女做爰猛烈刺激
|
99免费在线视频
|
五月天se|
久久99久久久久久久久久久
|
国产乱码一区二区
|
久操社区|
sm久久捆绑调教精品一区
|
国产污污视频在线观看
|
国产第一福利影院
|
成人性生交大片免费卡看
|
色亭亭|
99热日本
|
www.com黄色|
美女穴穴|
顶级黄色片
|
人妻精油按摩bd高清中文字幕
|
波多野吉衣一二三区乱码
|
黑人一级片
|
色七七桃花综合影院
|
美女免费视频网站
|
亚洲精品美女视频
|
国产黄色片在线播放
|
百合sm惩罚室羞辱调教
|
伊人视屏|
一区二区在线免费
|
曰本无码人妻丰满熟妇啪啪
|
婷婷视频在线
|
天天看天天做
|
91浏览器在线观看
|
摸大乳喷奶水www视频
|
蜜桃久久av一区
|
a√天堂资源
|
色天堂影院
|
少妇特黄一区二区三区
|
中文字幕看片
|
丰满熟妇人妻中文字幕
|
久久在线免费观看视频
|
香蕉网站在线观看
|
国产日韩欧美高清
|
成人夜晚视频
|
日本少妇一区二区三区
|
国产精品99久久久久久久久
|
亚洲不卡视频在线观看
|
天天看夜夜看
|
91精品在线观看入口
|
毛片网站在线播放
|
精品亚洲一区二区
|
成人小视频免费
|
一区二区三区美女视频
|
欧美在线观看网站
|
麻豆做爰免费观看
|
香蕉视频在线免费播放
|
免费视频成人
|
超碰免费在线观看
|
吃奶动态图
|
老牛影视av一区二区在线观看
|
波多野结衣国产
|
黄色片毛片
|
羞羞网站|
亚洲乱码在线
|
日韩色道|
亚洲成年人av
|
好色视频tv
|
青青插|
黄色片a|
国产日韩精品一区
|
女人张开腿让男人桶爽
|
亚洲欧美日韩国产精品
|
eeuss电影在线看免费观看
|
99香蕉网
|
中国少妇做爰全过程毛片
|
外国毛片
|
91国视频
|
免费视频成人
|
国产后入清纯学生妹
|
婷婷综合影院
|
精品人妻人人做人人爽夜夜爽
|
亚洲欧美日韩国产精品
|
午夜精品久久久久久久99热黄桃
|
亚洲精品电影网
|
好吊色视频988gao在线观看
|
特级毛片av|
免费小视频在线观看
|
欧美贵妇videos办公室
|
国产成人a∨
|
新x8x8拨牐拨牐永久免费影库
|
成人午夜视频网站
|
在线观看麻豆视频
|
看动漫的软件
|
久久伊人色|
高潮毛片无遮挡免费看
|
久久久国产精品视频
|
看av网址|
潘甜甜在线
|
日本熟妇浓毛
|
两口子交换真实刺激高潮
|
美国一级黄色大片
|
国产精品免费大片
|
九一网站在线观看
|
国产不卡毛片
|
亚洲美女一级片
|
特黄色一级片
|
日日热|
人与动物黄色片
|
日韩美女在线
|
一区二区三区四区五区六区
|
精品视频久久久久久
|
噜噜噜久久久
|
www.色综合
|
2024国产精品
|
av片在线观看
|
国产三级视频
|
丁香网站|
九七影院在线观看免费观看电视
|
色婷婷激情av
|
日韩一区2区
|
国产精品三级久久久久久电影
|
日韩av免费电影
|
嫩草影院懂你的影院
|
神马午夜精品
|
www一区二区|
中文字幕亚洲电影
|
激情导航
|
91精品国产aⅴ一区二区
|
视频推荐
|
亚洲一二三区在线观看
|
色小说av
|
久草视频免费在线观看
|
操到高潮视频
|
九九九色
|
国产小视频在线
|
黑料av在线
|
人妖黄色片
|
中国白嫩丰满人妻videos
|
免费观看91视频
|
免费观看黄色网址
|
黄色一级片毛片
|
香蕉视频在线免费播放
|
色www电影|
久久新视频
|
色网站在线观看
|
黄色一级视频免费看
|
欧美日韩国产大片
|
免费色网
|
色www电影
|
国产免费观看高清完整版在线
|
婷婷麻豆
|
蓝猫淘气三千问恐龙时代
|
国产精品久久久久久久久久久久久久久
|
怡红院成人av
|
国产精品主播一区二区
|
亚洲精品成人无码熟妇在线
|
亚洲午夜免费视频
|
国产小u呦5一10
|
在线观看av中文字幕
|
日韩av免费电影
|
欧洲xxxxx|
蜜臀av一区二区
|
日本中文字幕视频
|
加勒比综合
|
俺去俺来也在线www色官网
|
天天夜夜骑
|
99re只有精品
|
最色网站
|
欧美熟女一区二区
|
特种兵之深入敌后
|
午夜久久久久久噜噜噜噜
|
狠狠鲁视频
|
偷看娇妻享受粗大
|
国产成人精品一区二区三区在线
|
国产精品天天狠天天看
|
秋霞国产午夜精品免费视频
|
日本欧美亚洲
|
丰满岳乱妇在线观看中字无码
|
九九热在线视频观看
|
中文字幕在
|
亚洲成人午夜电影
|
一区二区三区视频在线免费观看
|
香蕉性视频
|
av亚洲在线|
我的大学私奴日记sm
|
丰满肉嫩西川结衣av
|
制服丝袜中文字幕在线观看
|
自拍偷拍电影
|
亚洲精品aa
|
黄色一级免费观看
|
一级片aaa|
电影一区二区
|
国产小视频在线
|
破处视频在线观看
|
日韩一区欧美
|
爱爱网视频
|
精品国产99久久久久久宅男i
|
一区二区三区视频网站
|
国产不卡毛片
|
黄金网站在线观看
|
国产小u呦5一10
|
污黄视频
|
亚洲va视频
|
伊人狼人久久
|
制服丝袜中文字幕在线观看
|
熟女少妇内射日韩亚洲
|
欧美成人亚洲
|
亚洲免费一级片
|
四虎永久免费
|
亚洲高清一区二区三区
|
97在线超碰
|
丝袜美腿亚洲综合
|
福利视频导航网
|
国产成人aaa
|
一区二区免费看
|
日剧网|
网友自拍av
|
国产在视频线精品视频
|
亚洲精品免费视频
|
日本精品视频一区二区三区
|
特黄色一级片
|
午夜福利一区二区三区
|
色狠狠一区二区三区香蕉
|
女同久久另类69精品国产
|
a天堂v|
黄色在线
|
久久精品久久久久久久
|
97超碰站|
五月天亚洲综合
|
91娇羞白丝
|
欧美成人午夜电影
|
亲女小嫩嫩h乱视频
|
亚洲精品国产精品乱码视色
|
av资源网站|
国产一区二区三区四区
|
久久艹久久
|
超碰最新在线
|
色播在线播放
|
另类在线视频
|
欧美日韩一区二区在线视频
|
久久国产精品一区二区
|
亚洲一区二区影视
|
成人久久精品人妻一区二区三区
|
国产女人和拘做受视频免费
|
国产精品国产精品
|
亚洲高清一区二区三区
|
中文字幕欧美在线
|
日韩中文一区二区
|
牛人盗摄一区二区三区视频
|
五月天激情影院
|
国产高清视频在线观看
|
免费精品视频
|
性视频在线
|
99久久国产综合精品成人影院
|
久久国产免费看
|
色乱码一区二区三区在线男奴
|
调教丰满的已婚少妇在线观看
|
欧洲女女同性videoso
|
亚洲第一网址
|
日韩成人在线播放
|
91蝌蚪在线
|
诱惑の诱惑筱田优在线播放
|
97精品国产97久久久久久免费
|
五月天激情四射
|
一极毛片|
国产拍拍视频
|
sleepless动画在线播放免费
|
日韩免费在线视频观看
|
欧美成在线视频
|
成人精品网址
|
日韩成人午夜电影
|
曰本无码人妻丰满熟妇啪啪
|
网站国产
|
麻豆md0077饥渴少妇
|
av亚洲成人|
亚洲av无码一区二区三区性色
|
黄色片一级片
|
欧美黑人性xxx猛交
在线少妇
|
无码人妻精品一区二区三
|
91福利网址
|
久久久国产精品
|
亚洲午夜在线视频
|
亚洲免费大片
|
午夜在线成人
|
日本精品少妇
|
五月天导航
|
国产高潮久久久
|
国产欧美一区二区视频
|
国产剧情一区二区
|
免费精品视频
|
欧美日本不卡
|
奇米一区
|
国产片在线|
国产精品偷伦视频免费观看了
|
精品久久久久一区二区国产
|
国产免费观看高清完整版在线
|
黄色网页在线免费观看
|
亚洲精品aa
|
奇米影视777第四色
日本不卡网
|
99久久国产综合精品成人影院
|
一区二区三区少妇
|
污污小视频
|
国产精品国产精品国产专区蜜臀ah
|
亚洲一二三区在线观看
|
亚洲+小说+欧美+激情+另类
|
极品少妇小说
|
91国产一区
|
国产亚洲小视频
|
久久久国产精品
|
欧美伊人|
免费一级淫片
|
秘密爱大尺度做爰呻吟
|
久久在线视频
|
诱惑の诱惑筱田优在线播放
|
成人久久精品人妻一区二区三区
|
激情综合图区
|
曰韩毛片
|
色二区
|
天堂在线资源网
|
亚洲美女一级片
|
黄色片a|
国产乱国产乱300精品
|
国产a国产片|
漂亮人妻被黑人久久精品
|
中文字幕自拍偷拍
|
色综合99久久久无码国产精品
|
成人综合激情
|
日本中文字幕视频
|
国产精品视频网址
|
天天看夜夜看
|
啪啪在线视频
|
国产精品入口麻豆
|
性xxxx欧美老肥妇牲乱
|
一级欧美视频
|
久久中文字幕无码
|
久久理论|
av片在线观看
|
伊人天堂av|
视频推荐
|
午夜久久久久久噜噜噜噜
|
国产女无套免费视频
|
成人播放器
|
一区二区三区av
|
a√在线观看
|
免费在线看黄网站
|
电影一区二区
|
91久久久久久久久久久
|
欧美激情一区二区三区
|
日韩久久久久久久久久久
|
深夜影院在线观看
|
亚洲国产精品久久人人爱
|
四虎影视在线播放
|
日本不卡网
|
欧美在线观看网站
|
狠狠插影院
|
亚洲精品一区二区三区新线路
|
精品国产成人亚洲午夜福利
|
欧美色拍
|
国产盗摄一区二区
|
国产精品免费一区二区三区都可以
|
日韩精品视频观看
|
狠狠干2019|
伊人av网|
17c在线观看
|
精品一区二区三区免费观看
|
免费av影视|
污污内射在线观看一区二区少妇
|
亚洲精品视频在线看
|
a视频在线免费观看
|
精品国产一级
|
双性懵懂美人被强制调教
|
久久在线观看视频
|
成人夜晚视频
|
蜜臀aⅴ国产精品久久久国产老师
|
男人av在线|
欧美在线小视频
|
欧美日日日
|
久草视频资源
|
爆操少妇|
特黄色一级片
|
91视频美女
|
极品少妇小说
|
免费a级黄色片
|
极品尤物魔鬼身材啪啪仙踪林
|
97精品人妻一区二区三区香蕉
|
欧美性区
|
人人叉人人
|
亚洲妇女无套内射精
|
污污视频免费观看
|
网爆门在线
|
www国产精品|
亚洲天堂一二三
|
性xxxx欧美老肥妇牲乱
|
日韩美女视频
|
sm久久捆绑调教精品一区
|
国产特级毛片aaaaaa
|
91丝袜在线
|
少妇资源|
手机在线精品视频
|
精品一区二区三区免费观看
|
欧美不卡一区二区
|
亚洲不卡视频在线观看
|
午夜福利理论片在线观看
|
特种兵之深入敌后
|
黄色网页在线免费观看
|
美女一级
|
男女在楼梯上高潮做啪啪
|
高中男男gay互囗交观看
|
波多野结衣国产
|
国产99免费
|
男人av在线|
免费网站www在线观看
|
国产欧美日韩在线
|
不卡的av在线播放
|
国产污污视频
|
欧美成人精品激情在线视频
|
日本电影成人
|
亚洲区自拍
|
黄色免费电影网站
|
手机看片在线观看
|
午夜视频在线免费观看
|
国产一级黄色电影
|
撸大师av
|
国产女主播喷水高潮网红在线
|
四虎影视在线播放
|
性少妇mdms丰满hdfilm
|
久久中文字幕无码
|
黑寡妇4免费完整在线观看
在线免费观看中文字幕
|
国产高清视频在线观看
|
婷婷色小说
|
成年人免费网站在线观看
|
99久久国产综合精品成人影院
|
亚洲午夜在线视频
|
91麻豆精品在线观看
|
国产视频成人
|
久操视频免费
|
高中男男gay互囗交观看
|
亚洲午夜网站
|
一区二区三区四区五区六区
|
久久激情网站
|
黄片毛片
|
日本精品在线观看视频
|
不卡视频一区
|
亚洲美女一级片
|
日韩色区
|
日本少妇裸体做爰
|
另类一区
|
婷婷麻豆
|
91成人在线视频
|
97在线超碰|
精品国产丝袜一区二区三区乱码
|
久久久资源
|
亚洲精品电影网
|
欧美午夜视频在线观看
|
www一区二区|
荡女精品导航
|
五月天激情影院
|
色婷婷一区|
国内精品嫩模av私拍在线观看
|
2024国产精品
|
久久久精品综合
|
99久久国产综合精品成人影院
|
国产特级毛片aaaaaa
|
少妇久久久
|
久久久国产精品
|
国模av在线
|
欧美日韩一区二区精品
|
久草久热
|
亚洲精品97久久中文字幕
|
激情成人av|
免费吃奶摸下激烈视频
|
日本精品视频在线观看
|
性少妇mdms丰满hdfilm
|
日韩欧美大片在线观看
|
日韩电影二区
|
按摩ⅹxxx性hd中国
|
成人午夜小视频
|
精品久久久久久久久久
|
黄色国产视频网站
|
久久网国产
|
亚洲aⅴ天堂av在线电影软件
|
99re只有精品
|
gogogo高清免费播放
|
欧美精品在线免费观看
|
国产乱国产乱老熟
|
欧美午夜精品久久久
|
极品91
|
妹子干综合
|
中文字幕一二三区
|
超碰免费在线观看
|
国产乱子伦精品
|
女人裸体又黄
|
国产图区|
春色视频|
国产乱码一区二区
|
一级久久久
|
樱空桃在线观看
|
曰本无码人妻丰满熟妇啪啪
|
国产精品三级久久久久久电影
|
99re这里只有精品6
|
嫩草影院懂你的影院
|
按摩ⅹxxx性hd中国
|
电影一区二区
|
明日花绮罗高潮无打码
|
国内黄色片
|
亚洲一二三区在线观看
|
涩涩av|
国产卡一卡二
|
www,五月天,com|
深夜影院在线观看
|
国产艳妇疯狂做爰视频
|
成年人网站免费观看
|
青草青青视频
|
亚洲网站在线
|
天海翼中文字幕
|
成人播放器
|
成人一区二区视频
|
一本久久综合
|
爱爱免费网址
|
国产福利视频一区二区三区
|
欧美黑人性xxx猛交
在线少妇
|
国产在线看片
|
另类图片亚洲色图
|
国产精品入口麻豆
|
波多野结衣一二区
|
摸大乳喷奶水www视频
|
女人与公拘交酡zozo
|
黄色网免费看
|
人妻精油按摩bd高清中文字幕
|
午夜精品久久久久久久99热黄桃
|
欧美日韩v
|
强睡邻居人妻中文字幕
|
不卡的av在线播放
|
国产福利在线观看视频
|
ass日本寡妇pics
|
国产精品污www一区二区三区
|
91超薄肉色丝袜交足高跟凉鞋
|
精品久久久久久久久久久久久久
|
五月天导航
|
最新av女优|
国内精品嫩模av私拍在线观看
|
日本中文字幕视频
|
日本精品在线观看视频
|
久久神马影院
|
免费视频成人
|
欧美特级毛片
|
日韩久久久久久久久久久
|
青草视频在线
|
亚洲午夜免费视频
|
美女免费视频网站
|
成年人免费网站在线观看
|
色网站在线观看
|
91国视频|
人与动物黄色片
|
日本美女毛茸茸
|
在线va|
羞羞软件
|
成人精品网址
|
蜜桃视频网页
|
久操资源|
日本人体视频
|
青草视频在线免费观看
|
少妇高潮露脸国语对白
|
人与动物黄色片
|
青青青视频在线播放
|
影音先锋在线视频观看
|
三级视频网址
|
成人久久精品人妻一区二区三区
|
男男h黄动漫啪啪无遮挡软件
|
国产精品天美传媒入口
|
亚洲成年人av
|
九九色在线
|
男人久久
|
国产精品国产一区二区三区四区
|
国内激情自拍
|
毛片a片免费看
|
亚洲欧美日韩国产综合
|
一级片特黄
|
天堂a√在线|
免费性视频
|
久久精品夜
|
污污内射在线观看一区二区少妇
|
俺去俺来也在线www色官网
|
亚洲最新
|
久久久国产精品
|
黄色一级电影
|
牛av在线
|
六十路息与子猛烈交尾
|
99久久国产综合精品成人影院
|
久久av资源|
亚洲国产区
|
国产91在线观看
|
手机看片在线观看
|
99热免费
|
香蕉视频在线免费播放
|
欧美午夜不卡
|
久久青娱乐
|
成人黄性视频
|
一级欧美一级日韩片
|
韩国av一区|
亚洲免费不卡视频
|
羞羞网站
|
免费国产精品视频
|
国产高清免费
|
国产后入清纯学生妹
|
高清国产视频
|
av观看网站
|
黄金网站在线观看
|
欧美影院一区二区
|
亚洲av无码一区二区三区性色
|
天堂中文8|
日韩精品人妻中文字幕有码
|
午夜福利一区二区三区
|
国产在视频线精品视频
|
日本wwww色
|
黑寡妇4免费完整在线观看
在线免费观看中文字幕
|
av资源网站|
99热99
|
国产精品入口
|
久久精品视频免费
|
亚洲免费不卡视频
|
嫩草影院在线免费观看
|
在线观看中文字幕亚洲
|
亚洲免费一级片
|
丰满白嫩尤物一区二区
|
久久av中文字幕
|
国产精品自拍99
|
婷婷综合亚洲
|
国产成人午夜精品
|
日本在线www
|
日韩一片
|
97国产精品视频
|
成人免费精品视频
|
麻豆md0077饥渴少妇
|
波多野结衣简介
|
让男按摩师摸好爽
|
国产八区
|
色播在线播放
|
欧美色频
|
亚洲色图激情
|
免费在线观看的黄色网址
|
久久久久久久久亚洲
|
国产在线高清视频
|
九九视频免费看
|
久久久久久久中文字幕
|
国产精品久久影院
|
国产精品电影
|
香蕉视频在线免费播放
|
日韩亚洲欧美一区
|
a视频在线免费观看
|
aaa在线播放|
激情六月
|
九九九九
|
青草视频在线观看免费
|
日韩中文字幕在线免费观看
|
91超薄肉色丝袜交足高跟凉鞋
|
国产日韩欧美精品
|
free黑人多人性派对hd
|
日本激情网
|
国产精品天美传媒沈樵
|
a天堂在线观看视频
|
一级黄色在线观看
|
欧美一区亚洲一区
|
免费成人黄色网
|
av综合站|
婷婷丁香色|
尤物天堂
|
欧美黑人性xxx猛交
在线少妇
|
国产精品不卡
|
波多野结衣vs黑人巨大
|
国产成人a∨
|
日韩草逼|
91久久久久久久久久久
|
色天堂影院
|
日本人做爰全过程
|
六十路息与子猛烈交尾
|
五月天激情影院
|
国产福利影院
|
男人和女人日批
|
久久精品第一页
|
久久99久久久久久久久久久
|
人人插人人干
|
明日花绮罗高潮无打码
|
国产成人a∨
|
亚洲区在线
|
自拍偷拍国产
|
按摩ⅹxxx性hd中国
|
精品一区二区三区四区
|
日本高清有码
|
日韩69|
日韩三级视频在线观看
|
波多野结衣简介
|
美腿丝袜亚洲色图
|
国产麻豆剧果冻传媒白晶晶
|
欧美黄色三级视频
|
草莓视频官网在线观看
|
在线中文视频
|
国产污污视频在线观看
|
少妇名器的沉沦
|
老司机精品导航
|
中国极品少妇videossexhd
一级片aaa
|
日韩成人在线播放
|
青娱乐精品
|
老熟妇一区二区三区啪啪
|
黄漫在线免费观看
|
夜夜干天天操
|
日本一区二区免费视频
|
天堂资源在线观看
|
婷婷在线免费视频
|
涩涩av|
九色在线视频
|
日日碰
|
狠狠人妻久久久久久综合
|
国产一区高清
|
在线观看午夜视频
|
禁网站在线观看免费视频
|
亚洲精品911
|
内地毛片
|
婷婷视频网
|
国产gay网站
|
日本高清视频免费看
|
h片在线播放
|
男女污污软件
|
激情综合图区
|
爽爽淫人网
|
四虎一区二区三区
|
一级欧美一级日韩片
|
久久久久久久久久一级
|
欧美成人黄色
|
国产97免费视频
|
p站在线观看
|
亚洲第一黄色网
|
欧美一区二区三区视频在线观看
|
欧美色拍
|
日本精品视频一区二区三区
|
日韩欧美自拍偷拍
|
在线天堂av
|
在线观看www.
|
高h喷水荡肉爽文1v1沉芙
|
综合影院
|
国产成人精品久久二区二区
|
在线视频 日韩
|
久久精品夜
|
91av官网
|
免费性视频
|
国产成人精品无码免费看夜聊软件
|
曰韩毛片
|
久久青娱乐
|
日本一区二区不卡
|
国产特级毛片aaaaaa
|
久久中文字幕人妻
|
一区二区三区视频在线免费观看
|
一区二区三区四区免费观看
|
日日碰|
熟女丰满老熟女熟妇
|
九九热精品视频在线观看
|
激情成人av
|
国产色站
|
老牛影视av一区二区在线观看
|
婷婷激情在线
|
亚洲福利视频在线
|
国产成人精品无码免费看夜聊软件
|
99热99
|
天天看天天做
|
a天堂在线
|
明日花绮罗高潮无打码
|
人人干天天操
|
18在线观看视频
|
让男按摩师摸好爽
|
日本免费不卡视频
|
日日操日日干
|
午夜视频在线播放
|
国产ts在线播放
|
91视频免费观看网站
|
久久伊人色
|
少妇激情网
|
色乱码一区二区三区在线男奴
|
黄色网免费看
|
特级西西人体wwwww
|
亚洲成人精品
|
av在线网页|
翔田千里在线播放
|
亚洲综合激情小说
|
草莓视频官网在线观看
|
美腿丝袜亚洲色图
|
男男h黄动漫啪啪无遮挡软件
|
日韩av视屏|
日韩一级黄色大片
|
日韩黄色免费视频
|
国产一级影院
|
手机看片在线观看
|
又粗又大又硬毛片免费看
|
国产精品视频网址
|
青草视频在线免费观看
|
国产福利影院
|
黄色xxxxx|
电影二区
|
国产精品原创
|
国产女人和拘做受视频免费
|
欧美特黄色片
|
国产精品国产精品
|
亚洲播放器
|
色呦呦一区二区三区
|
www.色综合|
懂色av蜜臀av粉嫩av分
|
天堂在线资源网
|
国产91高清
|
久久毛片基地
|
亚洲一二三区在线观看
|
日本不卡网
|
奇米影视888
|
gogogo高清免费播放
|
未满十八18禁止免费无码网站
|
91视频免费在线观看
|
曰本无码人妻丰满熟妇啪啪
|
91av在线免费观看
|
春色视频|
91高清免费
|
国产日韩精品一区
|
中文字幕亚洲电影
|
一区二区三区视频在线免费观看
|
色爽视频|
欧美三日本三级少妇99
|
青草视频在线观看免费
|
ass东方小嫩模pics
|
韩国精品久久久
|
色小说av|
在线观看免费人成视频
|
新婚之夜玷污岳丰满少妇在线观看
|
国模av在线
|
日本69视频
|
老熟妇一区二区三区啪啪
|
精品一区二区三区免费观看
|
av观看网站
|
日韩免费高清一区二区
|
亚洲av无码一区二区三区性色
|
老年人毛片
|
999热视频
|
强睡邻居人妻中文字幕
|
亚洲男人网
|
久久手机免费视频
|
韩国三级与黑人
|
九九小视频
|
中国美女一级看片
|
丰满熟妇被猛烈进入高清片
|
久久久国产精品视频
|
久久理论
|
午夜在线成人
|
在线免费观看中文字幕
|
亚洲成人二区
|
涩涩av|
不卡在线播放
|
亚洲精品911
|
日本在线黄色
|
日韩美女视频
|
破处视频在线观看
|
亚洲小视频在线播放
|
我不卡伦理
|
日韩av毛片|
国产精品一二三四
|
尤物天堂|
色偷偷亚洲
|
国内毛片毛片毛片
|
魔女鞋交玉足榨精调教
|
国产精品免费大片
|
日韩三级视频在线观看
|
四虎一区二区三区
|
久久网国产
|
91插插插视频
|
国产色播|
操人视频在线观看
|
国产真人做爰视频免费
|
www.色综合|
超碰人人人
|
中文字幕人妻色偷偷久久
|
久久在线免费观看视频
|
红桃视频国产精品
|
国产在线观看a
|
九九热精品视频在线观看
|
日本加勒比中文字幕
|
高h喷水荡肉爽文1v1沉芙
|
婷婷麻豆
|
懂色av蜜臀av粉嫩av分
|
免费色网
|
精品人妻人人做人人爽夜夜爽
|
人人干天天操
|
久久久久久久中文字幕
|
宝贝乖~胸罩脱了让我揉你的胸
|
亚洲女人18毛片水真多
|
国产艳妇疯狂做爰视频
|
不卡的av在线播放
|
久久毛片基地
|
男女一级片
|
中文字幕在线观看网址
|
午夜av免费看
|
日本色视频|
亚洲av人人澡人人爽人人夜夜
|
四虎永久网站
|
9.1人网站免费
|
国产999精品
|
丰满熟妇人妻中文字幕
|
亚洲电影第1页
|
亚洲区一区二区三区
|
欧美整片在线
|
九九精品在线播放
|
欧美精品偷拍
|
亚洲免费影院
|
撸大师av|
国产片在线
|
亚洲成人av网址
|
日韩精品视
|
偷看娇妻享受粗大
|
黄色片a|
少妇av在线
|
九九九色|
精品人妻人人做人人爽夜夜爽
|
国产精品天美传媒沈樵
|
日本少妇xxxx软件
|
欧美brazzers欧美护士
|
日本一区二区免费视频
|
亚洲AV无码一区二区三区少妇
|
亚洲精品久久久久久动漫器材一区
|
艳妇乳肉豪妇荡乳xxx
|
好吊视频在线观看
|
色呦呦一区二区三区
|
特级西西人体wwwww
|
久草视频免费在线观看
|
日韩久久免费视频
|
日本少妇在线
|
高中男男gay互囗交观看
|
日本啪啪网
|
少妇人妻丰满做爰xxx
|
www.777奇米|
视频污在线观看
|
久久国产精品一区二区
|
日韩av成人在线
|
久久成年视频
|
91久久在线
|
尤物精品
|
韩国黄色一级片
|
国产精品尤物
|
日本亲子乱子伦xxxx50路
|
日xxxx|
日本人体视频
|
一极毛片
|
羞羞漫画在线
|
亚洲精品911|
国产又粗又大又硬
|
黄漫在线免费观看
|
四虎一区二区三区
|
免费国产精品视频
|
美女免费视频网站
|
18在线观看视频
|
天天看天天做
|
男女激情网站
|
日本五十肥熟交尾
|
日韩免费高清一区二区
|
中文字幕第一区综合
|
亚洲专区av
|
俺去俺来也在线www色官网
|
人人看人人模
|
日韩欧美大片在线观看
|
美女穴穴
|
国产又粗又黄视频
|
免费小视频在线观看
|
潘甜甜在线
|
国产第一福利影院
|
欧美性猛交xxxx
|
激情综合婷婷
|
free黑人多人性派对hd
|
中国极品少妇videossexhd
一级片aaa
|
亚洲专区视频
|
日本道在线观看
|
成年人免费网站在线观看
|
免费a级黄色片
|
中文字幕日本在线
|
亚洲情热
|
国内精品小视频
|
九色在线视频
|
九色国产视频
|
亚洲视频天堂
|
红桃视频国产精品
|
韩国三级hd中文字幕叫床浴室
|
天海翼中文字幕
|
亚洲电影第1页
|
妹子干综合
|
免费国产精品视频
|
日韩三级视频在线观看
|
新婚之夜玷污岳丰满少妇在线观看
|
国产在线www|
欧美一区二区在线观看视频
|
欧美黄色三级视频
|
sleepless动画在线播放免费
|
天天夜夜骑
|
日韩免费毛片
|
日韩女优网站
|
精品人妻一区二区三区四区在线
|
波多野结衣中文字幕一区
|
狠狠干2019
|
www.好了av|
风流少妇
|
亚洲不卡视频在线观看
|
亚洲精品aa|
xxx性欧美|
日日夜夜天天
|
狠狠人妻久久久久久综合
|
新中文字幕
|
国产精品国产一区二区三区四区
|
免费国产|
婷婷深爱
|
狂野欧美性猛交xxxx
|
丰满白嫩尤物一区二区
|
婷婷狠狠操
|
九九色综合
|
曰本无码人妻丰满熟妇啪啪
|
蜜桃久久av一区
|
日韩美女在线
|
稀缺呦国内精品呦
|
午夜精品久久久久久久96蜜桃
|
亚洲av人人澡人人爽人人夜夜
|
尤物视频在线免费观看
|
一区二区在线免费
|
亚洲一区在线观看视频
|
亚洲xxx视频
|
欧美v在线|
av免费一区
|
国产精品va
|
激情视频网址
|
91av欧美|
女人裸体又黄
|
中文字幕在|
亚洲视频天堂
|
欧美伊人
|
国产高清视频在线观看
|
国产精品天美传媒入口
|
懂色tv|
成人香蕉视频在线观看
|
国产青青青|
国产精品九九九
|
99久久国产综合精品成人影院
|
亚洲精品无
|
a天堂在线资源
|
免费a网站|
国产成人小视频在线观看
|
欧日韩在线|
中国性老太hd大全69
|
成人h文|
97免费超碰
|
一区二区三区美女视频
|
日韩中文字幕视频在线观看
|
婷婷视频在线
|
亚洲aⅴ天堂av在线电影软件
|
91视频免费网站
|
亚洲男人的天堂网站
|
亚洲美女一级片
|
波多野结衣一二区
|
在线激情小视频
|
国产福利视频一区二区三区
|
本道久久|
操人视频在线观看
|
欧美性大战xxxxx久久久
|
日本japanese极品少妇
|
国产精品电影
|
福利精品在线
|
久草热在线观看
|
国产高潮久久久
|
日韩精品视频在线
|
日日碰|
xx久久|
人人爱操
|
中国少妇av
|
h片在线播放
|
亚洲国产精品久久人人爱
|
国产第一精品
|
精品99在线观看
|
色爽视频
|
成人颜色网站
|
日韩久久久精品
|
黄色一级电影
|
91丝袜在线
|
日本精品在线观看视频
|
欧美成人亚洲
|
国内精品小视频
|
天天弄天天操
|
青青插|
奇米一区|
久久在线观看视频
|
国产精品国产精品国产专区蜜臀ah
|
欧美图片第一页
|
操的我好爽
|
不卡视频一区
|
按摩毛片|
99无码熟妇丰满人妻啪啪
|
欧美一区二区三区视频在线观看
|
日韩久久免费视频
|
白浆网站
|
网友自拍av
|
亚洲午夜免费视频
|
国产亚洲系列
|
激情网站在线观看
|
亲女小嫩嫩h乱视频
|
污黄在线观看
|
老司机综合网
|
国产成人aaa|
99无码熟妇丰满人妻啪啪
|
九九热免费视频
|
国产乱人乱偷精品视频
|
欧美xx视频|
韩国成人免费视频
|
日韩成人av在线
|
老熟妇一区二区三区啪啪
|
四虎成人精品永久免费av九九
|
成人午夜小视频
|
久久久久久久久亚洲
|
三级黄网站
|
国产成人tv
|
97精品人妻一区二区三区香蕉
|
国产大片网站
|
亚洲精品久久久久久动漫器材一区
|
成人av在线影院
|
精品人妻一区二区三区浪潮在线
|
亚洲国产区|
成人小视频免费
|
最近最好的2019中文
|
日本美女毛茸茸
|
一区二区三区四区免费观看
|
成人夜晚视频
|
四虎影院国产精品
|
69堂在线观看
|
成人一区二区视频
|
欧美brazzers欧美护士
|
欧美色图一区二区三区
|
精品999视频
|
日xxxx|
亚洲青草视频
|
四虎影视在线播放
|
国产成人影视
|
www在线看片
|
欧美图片第一页
|
亚洲男人天堂2017
|
樱空桃在线观看
|
精品国产成人亚洲午夜福利
|
日韩久久久久久久久久久
|
黄色免费大全
|
国产大片网站
|
黄片毛片
|
丝袜美腿亚洲综合
|
大尺度做爰呻吟62集
|
91插插插视频
|
一区二区午夜
|
欧美日韩一区二区三区四区
|
92久久|
久久精品视频免费
|
午夜av免费看|
视频推荐|
欧美精品在线免费观看
|
a√天堂资源
|
久久在线观看视频
|
国产精品入口麻豆
|
诱惑の诱惑筱田优在线播放
|
93久久精品日日躁夜夜躁欧美
|
亚洲av人人澡人人爽人人夜夜
|
国产成人精品一区二区
|
91一区在线|
高h言情|
男女激情网站
|
成人夜晚视频
|
丰满肉嫩西川结衣av
|
成人久久精品人妻一区二区三区
|
夫妻av|
在线观看av中文字幕
|
97色资源|
韩国午夜影院
|
亚洲精品国产电影
|
91视频精选
|
久久在线视频
|
91一区在线
|
亚洲午夜小视频
|
天天干天天爱天天操
|
国产乱国产乱老熟
|
女人下部全棵看视频
|
av观看网站|
人人干天天操
|
色呦呦国产
|
亚洲欧美日韩国产精品
|
天天夜夜骑
|
最近最好的2019中文
|
97视频免费观看
|
婷婷中文在线
|
性v天堂
|
91视频精选
|
色综合久久av
|
亚洲美女免费视频
|
精品一区二区三区免费观看
|
性视频在线
|
色图视频
|
色小说av
|
久久久穴
|
精品国产乱子伦
|
日韩三级视频在线观看
|
国产福利视频一区二区三区
|
人妻精油按摩bd高清中文字幕
|
日韩熟女一区二区
|
亚洲日本一区二区
|
一本久久综合
|
日本韩国毛片
|
久久在线观看视频
|
精品久久久久久久久久
|
日韩精品视频观看
|
日本美女三级
|
成人h在线|
亚洲色图激情
|
97精品一区二区三区
|
看动漫的软件
|
神马午夜精品
|
欧美又大粗又爽又黄大片视频
|
东北少妇不戴套对白第一次
|
深夜福利久久
|
美国av导航
|
特种兵之深入敌后
|
四虎成人精品永久免费av九九
|
操的我好爽|
女人下部全棵看视频
|
久久久国产精品
|
99免费在线观看
|
日本免费不卡视频
|
亚洲依依|
亚洲a色
|
伊人av网|
久久精品夜
|
天天插天天透
|
婷婷视频在线
|
羞羞漫画在线
|
视频污在线观看
|
久久久久久久久亚洲
|
中国妇女做爰视频
|
亚洲妇女无套内射精
|
在线视频97
|
欧美大尺度做爰啪啪床戏明星
|
不卡的av在线播放
|
一区二区在线看
|
精品午夜视频
|
久久综合精品视频
|
成人h在线|
香蕉网站在线观看
|
黄色一级电影
|
婷婷在线免费视频
|
www网站在线观看
|
www.亚洲色图|
gogo人体做爰大胆裸体
|
夜夜干天天操
|
国产真人做爰视频免费
|
亚洲午夜在线视频
|
中文字幕不卡在线观看
|
尤物91|
国产片在线
|
少妇资源
|
免费网站www在线观看
|
久草久热
|
午夜www|
好吊视频在线观看
|
久久在线观看视频
|
春色视频
|
亚洲福利电影
|
亚洲区在线
|
成人颜色网站
|
99热日本
|
亚洲天堂一二三
|
另类二区
|
99精品一级欧美片免费播放
|
欧美色频
|
久久神马影院
|
伊人视屏
|
久久深夜福利
|
日韩视频免费观看
|
92久久|
天天摸夜夜添
|
国产欧美日韩久久
|
精品人妻无码一区二区三区换脸
|
亚洲爱情岛论坛永久
|
国产成人tv|
丰满岳乱妇在线观看中字无码
|
欧美中文在线观看
|
亚洲久久在线观看
|
日本久久中文字幕
|
日本色视频
|
五月婷婷综合在线
|
婷婷在线免费视频
|
国产99免费
|
国产精品欧美日韩
|
永久免费,视频
|
国产精华一区二区三区
|
国产麻豆剧果冻传媒白晶晶
|
91色视频|
久草视频在线免费看
|
韩国av一区
|
在线免费观看一区二区三区
|
天美传媒在线观看
|
性xxxx欧美老肥妇牲乱
|
伊人久艹|
欧美在线观看网站
|
www久久久久久
|
日韩三级黄色片
|
国产91高清|
日日干夜夜干
|
男人天堂2019
|
99热99
|
亚洲第一黄色网
|
妞妞影视
|
少妇久久久
|
国产精品va
|
91麻豆精品在线观看
|
欧美厕所偷拍
|
亚洲av人人澡人人爽人人夜夜
|
日韩精品一区二区视频
|
日日夜夜天天
|
欧美日韩精品在线观看
|
久久综合婷婷
|
精品久久久久久久久久
|
黑人一级片|
一区二区三区四区五区六区
|
久久成年视频
|
日本亲子乱子伦xxxx50路
|
av在线网页
|
日本精品视频一区二区三区
|
国产精品呻吟
|
国产专区在线
|
午夜久久久久久
|
精品人妻人人做人人爽夜夜爽
|
不卡中文字幕
|
亚洲女人18毛片水真多
|
水蜜桃91|
午夜影院在线免费观看
|
91久久在线
|
久久精品亚洲无码
|
蓝猫淘气三千问恐龙时代
|
日本人体视频
|
亚洲专区av
|
日本人体视频
|
在线免费观看中文字幕
|
精品久久久久久久久久久久久久
|
a三级黄色片
|
婷婷丁香色
|
精彩毛片
|
中文永久免费观看
|
国产成人午夜精品
|
男女做羞羞的视频
|
亚洲一区三区
|
91精品国产aⅴ一区二区
|
成人片在线看
|
一级片免费视频
|